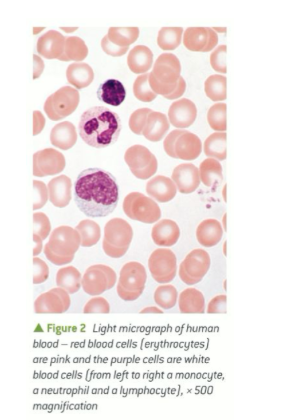

What is a Tissue:
A tissue is made up of a collection of differentiated cells that have a specialised function or functions.
As a result, each tissue is adapted for a particular function within the organism
There are four main categories of tissues in animals:
nervous tissue, adapted to support the transmission of electrical impulses
epithelial tissue, adapted to cover body surfaces, internal and external
muscle tissue, adapted to contract
connective tissue, adapted either to hold other tissues together or as a transport medium.
Specialised animal cells:
Squamous epithelium:
made up of specialised squamous epithelial cells, is sometimes known as pavement epithelium due to its flat appearance.
It is very thin due to the squat or flat cells that make it up and also because it is only one cell thick.
It is present when rapid diffusion across a surface is essential. It forms the lining of the lungs and allows rapid diffusion of oxygen into the blood.

Ciliated epithelium:
is made up of ciliated epithelial cells.
The cells have ‘hair-like’ structures called cilia on one surface that move in a rhythmic manner.
Ciliated epithelium lines the trachea, for example, causing mucus to be swept away from the lungs.
Goblet cells are also present, releasing mucus to trap any unwanted particles present in the air.
This prevents the particles, which may be bacteria, from reaching the alveoli once inside the lungs.

Cartilage:
is a connective tissue found in the outer ear, nose and at the ends of (and between) bones.
It contains fibres of the proteins elastin and collagen.
Cartilage is a firm, flexible connective tissue composed of chondrocyte cells embedded in an extracellular matrix.
prevents the ends of bones from rubbing together and causing damage.
Many fish have whole skeletons made of cartilage, not bone.

Muscle:
is a tissue that needs to be able to shorten in length (contract) in order to move bones, which in turn move the different parts of the body.
There are different types of muscle fibres.
Skeletal muscle fibres (muscles which are attached to bone) contain myofibrils (dark pink bands on the micrograph) which contain contractile proteins.
The skeletal muscle micrograph shown here has several individual muscle fibres (pink) separated by connective tissue (thin white strips).

There are a number of different tissues in plants, including
epidermis tissue, adapted to cover plant surfaces
vascular tissue, adapted for transport of water and nutrients.
examples of specialised tissues in plants:
The epidermis:
is a single layer of closely packed cells covering the surfaces of plants.
It is usually covered by a waxy, waterproof cuticle to reduce the loss of water.
Stomata, formed by a pair of guard cells that can open and close are present in the epidermis.
They allow carbon dioxide in and out, and water vapour and oxygen in and out.

Xylem tissue:
is a type of vascular tissue responsible for transport of water and minerals throughout plants.
The tissue is composed of vessel elements, which are elongated dead cells.
The walls of these cells are strengthened with a waterproof material called lignin (pink rings in the micrograph), which provides structural support for plants.

Phloem tissue:
is another type of vascular tissue in plants, responsible for the transport of organic nutrients, particularly sucrose, from leaves and stems where it is made by photosynthesis to all parts of the plant where it is needed.
It is composed of columns of sieve tube cells separated by perforated walls called sieve plates.

What is an Organ:
An organ is a collection of tissues that are adapted to perform a particular function in an organism.
For example, the mammalian heart is an organ that is adapted for pumping blood around the body.
It is made up of muscle tissue and connective tissue.
The leaf is a plant organ that is adapted for photosynthesis. It contains epidermis tissues and vascular tissue
Organ systems:
Large multicellular organisms have coordinated organ systems.
Each organ system is composed of a number of organs working together to carry out a major function in the body.
Animal examples of organ systems include:
the digestive system, which takes in food, breaks down the large insoluble molecules into small soluble ones, absorbs the nutrients into the blood, retains water needed by the body and removes any undigested material from the body
the cardiovascular system, which moves blood around the body to provide an effective transport system for the substances it carries
the gaseous exchange system, which brings air into the body so oxygen can be extracted for respiration, and carbon dioxide can be expelled.
differentiation.
The process of a cell becoming specialised
involves the expression of some genes but not others in the cell’s genome.
Stem cells
All cells in plants and animals begin as undifferentiated cells and originate from mitosis or meiosis.
They are not adapted to any particular function (they are unspecialised) and they have the potential to differentiate to become any one of the range of specialised cell types in the organism.
These undifferentiated cells are called stem cells.
Stem cells are able to undergo cell division again and again, and are the source of new cells necessary for growth, development, and tissue repair.
Once stem cells have become specialised they lose the ability to divide, entering the G, phase of the cell cycle
Why the activity of stem cells has to be strictly controlled:
If they do not divide fast enough then tissues are not efficiently replaced, leading to ageing.
However, if there is uncontrolled division then they form masses of cells called tumours, which can lead to the development of cancer.
What is stem cell potency:
A stem cell’s ability to differentiate into different cell types is called potency.
The greater the number of cell types it can differentiate into, the greater its potency.
Stem cells differ depending on the type of cell they can turn into
Types of cell stem cells can turn into:
Totipotent
Pluripotent
Multipotent
Totipotent
these stem cells can differentiate into any type of cell.
A fertilised egg, or zygote and the 8 or 16 cells from its first few mitotic divisions are totipotent cells, which are destined eventually to produce a whole organism.
They can also differentiate into extra-embryonic tissues like the amnion and umbilicus.
Pluripotent
these stem cells can form all tissue types but not whole organisms.
They are present in early embryos and are the origin of the different types of tissue within an organism.
Multipotent
these stem cells can only form a range of cells within a certain type of tissue.
Haematopoetic stem cells in bone marrow are multipotent because this gives rise to the various types of blood cell.
Differentiation:
Multicellular organisms like animals and plants have evolved from unicellular (single-celled) organisms because groups of cells with different functions working together as one unit can make use of resources more efficiently than single cells operating on their own.
In multicellular organisms cells have to specialise to take on different roles in tissues and organs.
They may be required to form barriers such as skin or be motile such as sperm cells.
Cells have adapted to different roles in an organism and so have many shapes (and sizes) and often contain different organelles.
Blood cells and their different functions:
Erythrocytes (red blood cells) and neutrophils (white blood cells) are both present in blood
They look very different because they have different functions.
When cells differentiate they become adapted to their specific role.
What form this adaptation takes is dependent on the function of the tissue, organ and organ system to which the cell belongs.
All blood cells are derived from stem cells in the bone marrow.
Replacement of red blood cells:
Mammalian erythrocytes are essential for the transport of oxygen around the body.
They are adapted to maximise their oxygen-carrying capacity by having only a few organelles so there is more room for haemoglobin.
Due to the lack of nucleus and organelles they only have a short lifespan of around 120 days.
They therefore need to be replaced constantly.
The stem cell colonies in the bone marrow produce approximately three billion erythrocytes per kilogram of body mass per day to keep up with the demand.
Replacement of white blood cells:
Neutrophils have an essential role in the immune system.
They live for only about 6 hours and the colonies of stem cells in bone marrow produce in the region of 1.6 billion per kg per hour.
This figure will increase during infection.


